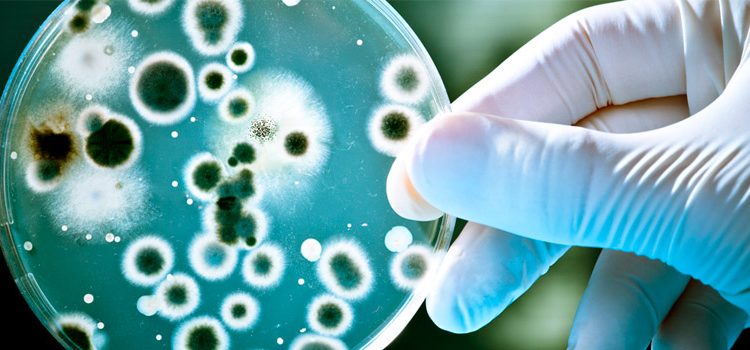

INVITAN A PROFESORES A PARTICIPAR EN EL CURSO TEÓRICO- PRÁCTICO “MICROBIOLOGÍA DEL SIGLO XXI”
El curso está dirigido a profesores de biología de establecimientos educacionales municipalizados de la Región de Coquimbo.
En el Departamento de Biología de la Universidad de La Serena se realizará desde el 10 al 13 de julio el curso teórico-práctico “Microbiología del Siglo XXI”, diseñado por la Red Latinoamericana de Ciencias Biológicas (RELAB) y patrocinado por la Fundación “Wellcome Trust” del Reino Unido, la Facultad de Medicina de la Universidad de Chile, el Programa de Educación en Ciencias de la Red Interamericana de Academias de Ciencias (IANAS), la Fundación Allende Connelly y la Facultad de Ciencias de ULS.
El curso se ha concebido como una instancia de formación profesional para los profesores y profesoras en tópicos avanzados en microbiología, para que puedan transmitir a sus alumnos el aprendizaje de conceptos fundamentales mediante materiales didácticos con el enfoque de la enseñanza de las ciencias basada en la indagación y mediante la visita de laboratorios portátiles a sus establecimientos educacionales, junto con estudiantes de postgrado que colaborarán en el montaje de los experimentos similares a los realizados en el curso.
La instancia busca contribuir al mejoramiento de la enseñanza – aprendizaje de la microbiología, mediante la capacitación teórica y práctica de profesores de biología de educación media de establecimientos municipales en cinco conceptos fundamentales de esta área de la biología moderna mediante el acceso a materiales y a equipamiento sofisticado para que los profesores puedan compartir sus experiencias con sus alumnos usando el enfoque indagatorio.
El curso, de 25 cupos, está dirigido a profesores de biología de establecimientos educacionales municipalizados de la Región de Coquimbo y no tiene costo para los docentes participantes.
La Facultad de Ciencias de la Universidad de La Serena entregará una constancia de asistencia y calificación.
Los profesores del curso son Lorgio E. Aguilera (coordinador), Claudia Barraza (microbiología clínica), Alex Cea (microbiología de alimentos), Verónica Plaza (microbiología molecular), Luis Castillo (micología molecular), Francisco López (didáctica de las ciencias), Gloria Núñez (didáctica de las ciencias) y Héctor Bugueño (didáctica de las ciencias).
Para postulaciones, los interesados deben contactarse con los profesores Lorgio Aguilera y Francisco López a los correos laguiler@userena.cl y flopez@userena.cl o a los teléfonos 56 51 2204418 – 56 51 2204322.
Programa: Curso Microbiología del Siglo XXI_2017